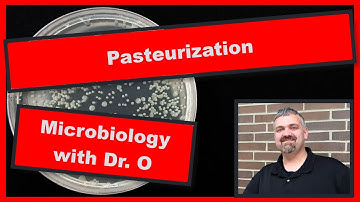
Pasteurization:  Microbiology

⬇ DOWNLOAD NOW
Kalau muncul iklan pop-up, tutup lalu klik tombol kembali
Download lagu Pasteurization: Understanding Types, Processes, and Uses in Food Microbiology - Microbiology Courses secara gratis hanya untuk keperluan promosi. Dukung artis favorit kamu dengan membeli musik original di iTunes atau platform resmi lainnya.
Pasteurization: Microbiology
Pasteurization: Microbiology
 What Is Fermentation and How Does It Work? | Successful Fermentation Tips | Esco Lifesciences
What Is Fermentation and How Does It Work? | Successful Fermentation Tips | Esco Lifesciences
 What is Pasteurized milk? | Ask Organic Valley
What is Pasteurized milk? | Ask Organic Valley
 Microorganisms | The Dr. Binocs Show | Educational Videos For Kids
Microorganisms | The Dr. Binocs Show | Educational Videos For Kids
 Pasteurization Explained: Benefits, Methods & Examples | Milk, Wine & More @EnteMicrobialWorld
Pasteurization Explained: Benefits, Methods & Examples | Milk, Wine & More @EnteMicrobialWorld
 What is Pasteurization? | Things to Know |
What is Pasteurization? | Things to Know |
 Making Yoghurt | Health | Biology | FuseSchool
Making Yoghurt | Health | Biology | FuseSchool
 Micro-Biology: Crash Course History of Science #24
Micro-Biology: Crash Course History of Science #24